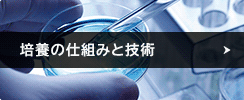
培養の仕組みと技術

正規のCRF療法を提供している認可施設ということを患者様が認知できるよう、「CRF認証シール」を発行しています。
セルチャーとは、コンデンスリッチファットに、培養した幹細胞を添付した脂肪のことです。豊富に含まれた幹細胞が、脂肪の定着を助けるので、より高い定着率が期待できます。主に豊胸手術に用いられますが、2018年以降は、乳がん後の乳房再建手術にも使用されるようになりました。
幹細胞の培養は、20~30mLのごく少量の脂肪細胞を元手に行います。「CELLPORTER」という専用キットで脂肪を採取し、厚生労働省が認可した専門施設で、幹細胞の抽出と培養を行います。培養期間は、検査も含めておよそ3~5週間です。
幹細胞の含有量が豊富
脂肪由来幹細胞(ADSC)は、様々な脂肪に分化する多能性を持つ体性幹細胞の一種です。注入先で、血管内皮細胞や脂肪細胞となって、脂肪の定着を助けます。血管内皮細胞に分化したADSCは、脂肪細胞に栄養を届ける役割を果たし、脂肪細胞に分化したADSCは、術部のボリュームを維持する役割を果たします。
セルチャーは、従来の幹細胞注入法と比較して、およそ7.5倍もの脂肪由来幹細胞を含んでいます。
1ccあたりの細胞密度が高いCRFを使用
たとえ幹細胞が豊富に含まれていても、それを添付する注入脂肪が良質でなければ、その効果は半減してしまいます。そこでセルチャー注入では、不純物を取り除いた脂肪、コンデンスリッチファット(CRF)を用います。CRFは、肥大した老化細胞や、死亡細胞、麻酔液などを取り除いたクリーンな脂肪です。1ccあたりの細胞密度が高く、採取した脂肪をそのまま注入する従来法と比較して、より多くの細胞を注入できます。
- 従来法とCRFのボリューム/セルカウント比較
-
従来法 CRF %CRF 
50ml 43mL 86% 1.29 x 10(6)/mL 1.63 x 10(6)/mL 126% 
55ml 35mL 63% 1.62 x 10(6)/mL 2.29 x 10(6)/mL 141% 
50ml 35mL 70% 1.43 x 10(6)/mL 2.24 x 10(6)/mL 166% 
51.6ml 37.6mL 72% 1.44 x 10(6)/mL 2.05 x 10(6)/mL 144% - 従来法よりボリューム(量)が少なくとも、細胞数は多いことが明らかに
採取する脂肪量はごくわずか

これまで幹細胞を豊富に含む脂肪注入法としては、幹細胞脂肪注入が一般的でした。しかし、幹細胞脂肪注入の場合、注入する脂肪と同量の脂肪を採取してそこから幹細胞を抽出するため、大量の脂肪採取が必要で、痩せている方には不向きという難点がありました。これを払拭したのがセルチャー注入です。セルチャー注入では、幹細胞の抽出に必要な脂肪はたったの20mL。痩せている方でも、幹細胞を豊富に含んだ脂肪の注入が可能になったのです。
体への負担を軽減

セルチャー注入は、2つの理由から体に低負担な脂肪注入だと言えます。
ひとつは、脂肪の採取量が少ないという理由です。脂肪注入では、脂肪の採取量が増えれば増えるほど、損傷範囲が広く、体はダメージを受けます。その点セルチャー注入は、わずか20mLの脂肪を培養する方法です。体へのダメージを最小限に抑えることができます。
もうひとつは、手術時間が短いという理由です。施術時間が長ければ長いほど、投与する麻酔の量が増え、体に大きな負担がかかります。幹細胞脂肪注入では、脂肪注入と同日に幹細胞を抽出するため、4〜6時間の手術時間が必要です。この間、ずっと麻酔を投与したままなので、目覚めたときに、寒気や吐気などを感じやすくなります。その点セルチャー注入は、事前の脂肪採取が20〜30分、脂肪注入が2〜3時間の手術です。麻酔を投与される時間が、幹細胞脂肪注入の半分以下になり、体への負担が減りました。
幹細胞培養の仕組み
脂肪採取

セルチャー注入では、専用のキット「CELLPORTER」を使用することで、スムーズな脂肪採取が可能です。脂肪吸引用カニューレに付属品のVacLok(脂肪吸引用シリンジ)を取り付け、腹部や上腿部から20mL程度の脂肪を吸引します。これをCELLPORTER で梱包し、厚労省が認可した専門施設に送ります。
培養

専門施設に届いた脂肪はバーコードで個別に管理されます。幹細胞の抽出と培養は、クリーンレベルの極めて高い環境下で行われ、幹細胞数は3週間かけて、およそ3,000万個になります。さらにその後、2週間かけて無菌試験、マイコプラズマ否定試験、エンドトキシン試験が行われ、安全性が確認されたもののみ、医療機関に返送されます。
セルチャー生成の仕組み
培養幹細胞は返送時、凍結保存された状態で届きます。これをウォーターバスを用いて解凍し、不要物質を破棄して、CRFに添付します。セルチャーの完成です。
これを術部に注入します。
※CRFの生成については「CRF抽出の仕組みと技術」をご覧ください。
脂肪採取から培養幹細胞添加までの流れ
-

- 脂肪細胞を採取(20ml)
-

- 専門施設で幹細胞を抽出・培養
-

- スピッツ1本あたり約250万個の幹細胞
-

- フレッシュな脂肪に幹細胞を添加して注入
脂肪注入のプロセスの比較
![]() |
![]() |
|---|---|
![]() |
![]() |
| 注入する脂肪に対して幹細胞の割合が多く、高い効果が期待できる。その一方で、幹細胞を抽出した脂肪は破棄してしまうため、採取した脂肪の半分が無駄になってしまう。 | コンデンス技術で脂肪の定着に不利な不純物の他、肥大化した老化細胞も破棄。そこに事前に培養しておいた幹細胞を加える。1ccあたりの健全な脂肪と幹細胞の密度が高まるため、注入できる細胞数が多く、高い定着率が見込める。 |
施術比較(バスト・胸の場合)
![]() |
![]() |
|
|---|---|---|
| 治療内容 | 吸引した自分の脂肪組織から幹細胞を抽出し、注入用脂肪とともにバストに注入する。 | 吸引した自分の脂肪を濃縮してCRFを生成。ここに培養脂肪幹細胞を加えて、セルチャーとした脂肪をバストに注入する。 |
| 適応 | 肥満体型の方 (採取可能な脂肪が十分あること) |
肥満体型〜痩せ型の方まで 乳がん後の乳房再建を望む方 |
| 触感 | 自然 | 自然 |
| 形 | 自由 | 自由 |
| サイズ | 1〜2カップ程度 | 1〜2カップ程度 (乳房再建の場合は不定) |
| 持続効果 | 長い | 長い |
| 施術時間 | 最低でも6時間 | 事前の脂肪採取:20〜30分 脂肪注入:2〜3時間 |
| 注入する 脂肪の質 |
コンデンスされていない幹細胞脂肪 (死活・老化細胞を含む) |
コンデンスされた健全な脂肪細胞(CRF)に培養脂肪由来幹細胞を添付したもの。 |
| FDA公認 | なし | なし (CRF抽出時に使用するLIPOKITとLIPMAX-SCは、 FDAの認可を受けています) |
| 術後の痛み | 比較的軽度〜中等度(吸引量が多い場合) | 比較的軽度 |
| 主な合併症 | 少ない | 少ない |
| メリット | 脂肪吸引による痩身効果もある | 脂肪吸引による痩身効果もある |
豊胸・バストアップ(セルチャー豊胸)
セルチャーは、細身の方の豊胸手術や、乳がん後の再建手術に適しています。